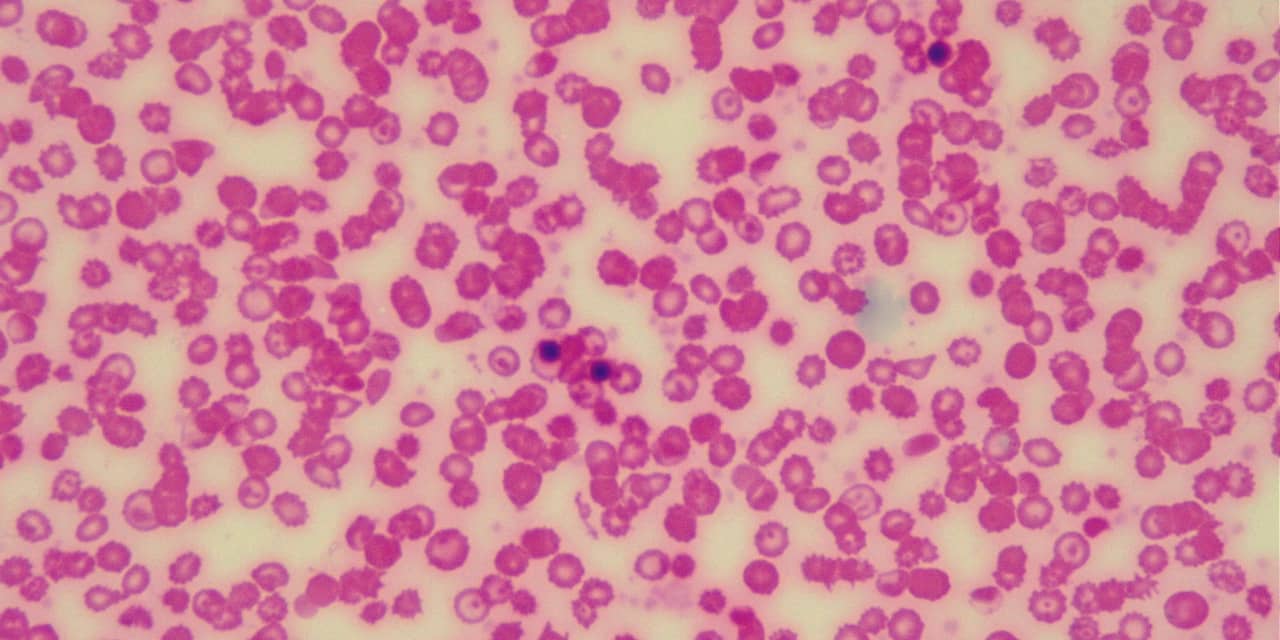

Global Blood Therapeutics Acquisition
Global Blood Therapeutics GBT remains on track for Voxelotor commercialization in 2020. You are now leaving the Global Blood Therapeutics website You are currently leaving our site.
Global Blood Therapeutics reported a strong Q42020 despite COVID-19 headwinds.

Global blood therapeutics acquisition. Do you like to find about Top Level of Executives and Decision makers of companies like Global Blood Therapeutics. GBT is in the process of developing GBT440 to reduce the severity and frequency of crises and pain associated with. A report by Reuters noted that Danish drugmaker Novo Nordisk AS ADR NYSENVO has approached Global Blood Therapeutics to discuss a potential acquisition of the company currently in Phase 3 testing for its lead pipeline candidate GBT440 a once-daily pill for.
Zacks Investment Research upgraded Global Blood Therapeutics from a sell rating. Reuters - Danish drugmaker Novo Nordisk AS NOVObCO has approached Global Blood Therapeutics Inc GBTO a US. Novo meanwhile has been at work on its hemophilia franchise though its biggest efforts.
GBT announced that it had received FDA approval for its drug Oxbryta voxelotor in treating adults. Eric Fink Chief Human Resources Officer. Global Blood Therapeutics Inc.
GBT is in the process of developing GBT440 to reduce the severity and frequency of. Global Blood Therapeutics Acquisition Value Could Be At Least 3 Billion Global Blood Therapeutics Inc NASDAQ. Patients with sickle cell disease have seen their treatment options expand in the last couple of years and one new therapy that has hit the ground running is.
Global Blood Therapeutics NASDAQGBT had its target price reduced by Canaccord Genuity from 4500 to 4000 in a report issued on Wednesday Benzinga reports. The Global Blood Therapeutics earnings report also has its net loss coming in at 5988 million. Roche was using it in a phase 2 study to treat patients.
Fink joined GBT in August 2019 as chief human resources officer. They do not constitute an endorsement or an approval by Global Blood Therapeutics. Global Blood Therapeutics GBT is a biopharmaceutical company dedicated to the discovery development and delivery of life-changing treatments that provide hope to underserved patient communities.
He is responsible for all aspects of the companys human resources HR function including talent acquisition talent management employee engagement. NASDAQGBT South San Francisco The companys new treatment for sickle cell disease was approved by the Food and Drug Administration less than a year ago. Were looking for exceptional individuals who share our commitment to use the power of science empathy and community to transform the lives of patients with sickle cell disease SCD a devastating and overlooked blood-based disorder.
External links are being provided as a convenience and for informational purposes only. Global Blood acquired the rights of inclacumab from Roche OTCQXRHHBY OTCQXRHHBF in a deal that was generated back in August of 2018. Global Blood Therapeutics Inc NASDAQ.
Global Blood Therapeutics inks deal for two sickle cell disease drugs from Sanofi In acquiring the two early-stage Sanofi drugs for sickle cell disease Global Blood Therapeutics aims. Founded in 2011 GBT is delivering on its goal to transform the treatment and care of sickle cell disease SCD a lifelong devastating inherited blood disorder. Several other equities research analysts also recently commented on the company.
Oxbryta is expensive at a cost of 125000 a year. Careers More than a career its a cause. Global Blood Therapeutics NASDAQ.
Check the professional list by Designation Email Id Mobile and Social Profile and more. They currently have a hold rating on the stock. This is a 72 narrower net loss than the 6455 million reported in.
Shares of Global Blood Therapeutics Inc NASDAQGBT spiked up in early trading to close up 21 to 3425. Global Bloods lead therapy is for sickle cell disease with a big focus on blood disorders. The companys flagship product Oxbryta is off to a great start with a.
Investors can also anticipate eventual separation on vasoocclusive endpoint to rally shares. Biotechnology company focused on serious blood disorders to discuss a potential.
 Global Blood Therapeutics Stock Sell Off Alters My Investment Strategy Gbt Seeking Alpha
Global Blood Therapeutics Stock Sell Off Alters My Investment Strategy Gbt Seeking Alpha
 7 Global Blood Therapeutics Fiercebiotech
7 Global Blood Therapeutics Fiercebiotech
 Global Blood Therapeutics Inc Sec Registration
Global Blood Therapeutics Inc Sec Registration
 Global Blood Therapeutics Stock Sell Off Alters My Investment Strategy Gbt Seeking Alpha
Global Blood Therapeutics Stock Sell Off Alters My Investment Strategy Gbt Seeking Alpha
 Eric Fink Global Blood Therapeutics
Eric Fink Global Blood Therapeutics
Jeffrey Farrow Global Blood Therapeutics
Jeffrey Farrow Global Blood Therapeutics
 Global Blood Therapeutics Inc Sec Registration
Global Blood Therapeutics Inc Sec Registration
 Jung E Choi Global Blood Therapeutics
Jung E Choi Global Blood Therapeutics
 Global Blood Therapeutics Stock Sell Off Alters My Investment Strategy Gbt Seeking Alpha
Global Blood Therapeutics Stock Sell Off Alters My Investment Strategy Gbt Seeking Alpha
 Global Blood Therapeutics Stock Sell Off Alters My Investment Strategy Gbt Seeking Alpha
Global Blood Therapeutics Stock Sell Off Alters My Investment Strategy Gbt Seeking Alpha
 Gbt Picks Up Roche S Dropped Heart Drug For Its Sickle Cell Disease Pipeline In 127m Deal Fiercebiotech
Gbt Picks Up Roche S Dropped Heart Drug For Its Sickle Cell Disease Pipeline In 127m Deal Fiercebiotech
 Global Blood Therapeutics Inc Sec Registration
Global Blood Therapeutics Inc Sec Registration
 Global Blood Therapeutics Inc Sec Registration
Global Blood Therapeutics Inc Sec Registration

 Global Blood Therapeutics Stock Sell Off Alters My Investment Strategy Gbt Seeking Alpha
Global Blood Therapeutics Stock Sell Off Alters My Investment Strategy Gbt Seeking Alpha
 Tricia Suvari Global Blood Therapeutics
Tricia Suvari Global Blood Therapeutics
Gbt Expands Sickle Cell Disease Pipeline With Exclusive

Post a Comment for "Global Blood Therapeutics Acquisition"